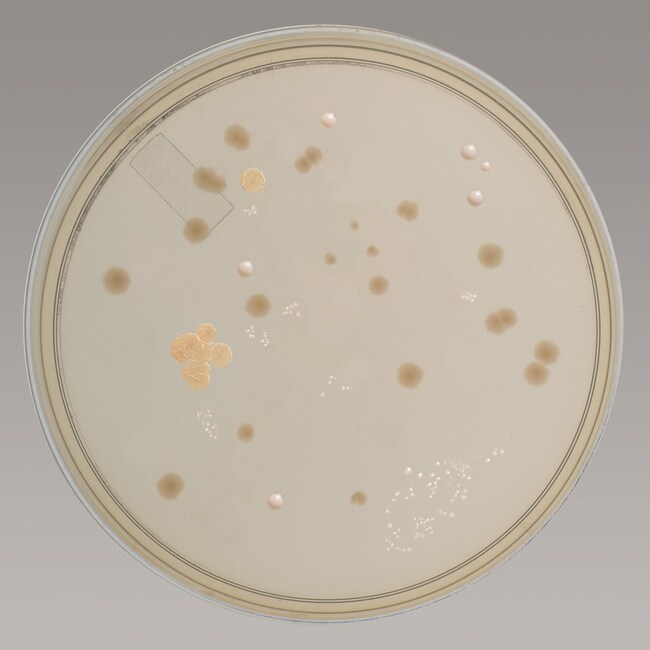
无菌沉降板 R2A

Search
Search
使用无菌 R2A 沉降板对饮用水中的异养细菌进行计数和培养。
| 货号 | dimFormat |
|---|---|
| R111970 |
使用 Thermo Scientific™ Remel™ 无菌 R2A 沉降板,对饮用水中的异养细菌进行计数和培养。使用营养较低的培养基、较低的孵育温度和更长的孵育时间,刺激从处理过的水中回收的应激和耐氯细菌的生长。美国公共卫生协会 (APHA) 在水和废水检验的标准方法中推荐使用 R2A 琼脂1。关于水质(如异养细菌平板计数)的信息可用于评估处理工艺的效率。
使用 R2A 琼脂对饮用水中的异养细菌进行计数和培养。美国环境保护署的 Reasoner 和 Geldreich 开发了 R2A 琼脂,用于从处理过的饮用水样本中分离和回收需氧细菌和兼性异养细菌3。与营养丰富的培养基相比,在营养较低的这款培养基中,从处理过的饮用水中获得的细菌计数更高,因为这些细菌往往是生长缓慢的种属,在营养更丰富的培养基上会很快被生长较快的种属抑制。
该培养基含有蛋白胨,其可提供细菌生长所必需的含氮化合物和氨基酸。添加了葡萄糖,作为能量的碳源。酵母提取物提供了 B 族复合维生素,用作生长促进剂。添加了可溶性淀粉(作为中和剂)和丙酮酸钠,以刺激应激细菌生长。缓冲剂(如磷酸氢二钾和硫酸镁)可维持渗透平衡。
并非所有产品在所有国家(地区)均有售。详情请具体咨询。
Remel™ 和 Oxoid™ 产品现已归属 Thermo Scientific 品牌旗下。